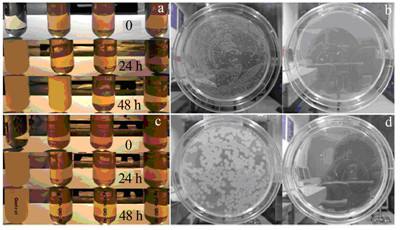

我国水资源污染严重,随着污染的恶化,人们环境意识的提高,国务院及环境保护部制定了一系列环境保护方面的意见与规划,其中包括: “十二五”期间,到2015年,消除劣质水体,改善城市水环境;投入相当大的人力、物力、财力防治大气污染和水污染;重新设定排污标准。随着相应制度和措施的落实,迫切需要环境治理技术的改进,及新型有效处理材料的研究〔1〕。水污染主要包括有机物(如染料等)污染、无机物(如金属离子等)污染和微生物污染。目前,膜处理和吸附技术因其独特的特点已广泛应用于众多领域的废水处理中,但在其应用中还存在一系列实际问题需要改进。目前,一种应用效果好、应用前景广阔的新星――多巴胺备受科研人员的关注。笔者就多巴胺这一物质,对其特点、作用机理、在膜技术和吸附方面的应用及前景进行了介绍。
1 多巴胺的自聚-附着行为及其机理
多巴胺(dopamine),一种生物神经递质。2007年,H. Lee等〔2〕从贻贝的黏附蛋白中获得启发,利用多巴胺研究了其在不同有机、无机材料表面的自聚涂覆功能,并成功形成了功能化的改性表面。自此,有关多巴胺在除神经学外的应用报道不断引起人们的关注。基于多巴胺的黏附性、还原性以及生物相容性,多巴胺及其衍生的复合粒子逐渐被用于各个领域,如抗菌〔3〕、催化〔4〕、生物传感器〔5〕、细胞成像〔6〕、膜技术、吸附等。尽管多巴胺具体的黏附机理还不是很清楚,但是科研人员普遍认为,这种性能与多巴胺所含有的邻苯二酚和氨基官能团有关。其中被广泛接受的解释有2种,一种是在不同的pH下,多巴胺自聚后所带电荷不同(见图 1)〔7〕,从而使得其所附着的材料表现出不同的功能;另一种是在水溶液中,多巴胺的邻苯二酚基团容易被氧化,生成含有邻苯二醌结构的醌化合物,多巴胺和其醌化合物发生反歧化反应,产生醌自由基,耦合形成交联键,从而在基体材料表面形成紧密附着的交联复合〔8〕。这与随后发现的多巴胺表现出还原性能〔9〕具有一致性。从多巴胺和氧化石墨烯的反应(见图 2)可直接观察到,混合了多巴胺的氧化石墨烯经过滤后,颜色变黑,说明氧化石墨烯被还原〔9〕。随着多巴胺在除神经学领域外应用的增多,需对其作用机理进行深入研究,从而使其得到更广泛的应用。

图 1 不同pH下多巴胺自聚后的带电情况

图 2 经氧化石墨烯过滤后的膜(a)与经聚多巴胺(PDA)修饰后的氧化石墨烯过滤后的膜(b)的比较
2 多巴胺用于膜技术
膜处理技术〔10〕因其分离效率高、设备简单、操作方便、无相变、节能等优点,已被广泛应用于石油化工、医药卫生、冶金、电子、能源、轻工、纺织、食品、环保、航天、海运等的废水处理中,其作用不可小觑。而膜材料又是膜技术的核心,因此,弥补现有膜材料使用中易污染、难清洗、寿命短、成本高等不足,提高膜材料的性能,是目前亟待解决的问题。由于表面功能化改性不改变膜本体结构,仅有效改变材料表面的性能,其受到研究者的广泛关注。基于多巴胺的黏附功能,其多被用于材料的表面功能改性。B. D. McCloskey等〔11〕在2010年用多巴胺对膜进行改性,研究了改性后的反渗透膜、超滤膜和微滤膜在水通量和抗污性方面的改变。研究表明,所有膜经过多巴胺改性后,对蛋白质和牛血清白蛋白的黏附减少,说明其抗污性增强;然而,经过改性后,虽然亲水性增强,但是由于膜孔被部分堵塞,其水通量有不同程度的减少。由于经多巴胺修饰后的膜的部分效果可得到增强,研究者对此进行了广泛研究。J. T. Arena等〔12〕用多巴胺对反渗透膜进行表面修饰,研究发现,改性后的膜比未改性膜的水通量可高出8~15倍。从多巴胺改性前后膜的电镜图(见图 3)可以看出,改性后的膜孔被适量的多巴胺填充。经多巴胺改性后,膜材料的亲水性增强,从而使得膜的水通量增大,这对其在工程中的应用有很大价值。Gang Han等〔13〕的研究表明,聚多巴胺(PDA)镀膜过程对实验结果有很重要的影响。基于前面的研究,S. Kasemset等〔14〕对多巴胺改性中多巴胺浓度、pH、沉积时间等因素对膜水通量、截盐率、油水分离的影响进行了研究,实验表明,膜的纯水通量随着多巴胺浓度的增大、沉积时间的增长而减少;在任意浓度、沉积时间及碱性条件下,其抗油污性都显著增强。综上,多巴胺是很好的膜表面改性材料。由于对于多巴胺改性的机理、最佳工艺条件,以及如何综合提升各种效果还没有切实的研究,因此,距离实际生产应用还有距离。

图 3 原始膜孔结构(a)与聚多巴胺(PDA)镀膜后的膜孔结构(b)的比较
3 多巴胺用于吸附
吸附因其易操作、成本低,成为化学工业、石化工业、制药工业的一种重要分离手段。吸附剂的吸附容量、吸附效率以及可循环利用能力是其得以广泛应用的重要考量。基于多巴胺的亲水性以及自身的黏附性,N. Farnad等〔15〕将其制成单独的聚多巴胺纳米粒子作为新型吸附剂移除水溶液中的Cu(Ⅱ)。在碱性溶液中,可通过多巴胺自聚形成聚多巴胺粒子,其平均直径为75 nm。吸附试验表明,聚多巴胺粒子移除Cu2+的能力能达到34.4 mg/g。可见,多巴胺是很有前景的吸附材料。基于此,不少研究者将多巴胺与其他吸附类材料结合在一起,从而增强了吸附效果。众所周知,活性炭是一种优良的吸附剂,其具有独特的孔隙结构和表面活性官能团,并具有稳定的化学性能,耐强酸、强碱、高压等优点。石墨烯作为活性炭的一种同素异形体,因其独特的平面及超大的比表面积,受到研究者的广泛关注。石墨烯以及基于石墨烯的衍生物已用于重金属离子以及有机染料的去除〔16〕,研究证明,其具有良好的除污效果。综合多巴胺与石墨烯的特性,两者的复合材料已被制备,并用于抗菌〔3〕、催化〔4〕等。图 4显示了Ag-PDA-石墨烯形成的复合粒子对革兰氏阳性菌和革兰氏阴性菌的抗菌效果。定性实验表明,形成的复合粒子有很强的抗菌性能,为污水中微生物的去除提供了思路。
图 4 Ag-PDA-石墨烯复合粒子对E.coil (a,b)和B.subtilis (c,d)的抗菌效果
为了方便工业大规模应用,效率高、成本低、易回收的吸附材料一直是研究的重点。在普遍想做精做细的同时,有研究者以逆向思维考虑,把2D的复合粒子转变为3D的复合材料,克服了2D复合粒子难回收的难题〔17〕。Hongcai Gao等〔18〕将多巴胺与氧化石墨烯进行结合(见图 5)形成3D水凝胶,并用于水的净化。由于两者独特的性能,凝胶形成过程简单。吸附实验证明,多巴胺与氧化石墨烯复合凝胶对重金属、合成染料以及芳香族污染物都表现出了很高的吸附能力,更重要的是,污染物被吸附后这种独立的3D结构很容易被回收,而且通过简单的pH调节和乙醇冲洗还可以使3D复合凝胶循环再利用。这不但简便了操作,也大大降低了回收成本,对于实际的工业操作有很大的应用价值。

图 5 聚多巴胺功能化的石墨烯凝胶用于污水净化的简易图示
多种吸附剂制备的复合材料,因其效率高,值得研究者不断挖掘。而这其中,多巴胺又是不得不关注的交联剂。。
4 结语与展望
膜技术和吸附技术作为效率高、无污染的绿色处理技术,其工艺和实际应用水平在不断提高,必将更广泛地应用于工业废水和生活污水的处理。多巴胺作为一种绿色物质,结合其自身自聚、黏附、还原等特性,在污水处理中有着独特的作用。针对多巴胺在吸附和膜技术方面的应用研究,以下几方面的工作值得进一步开展:
(1)对于多巴胺自聚-复合的机理研究还需进一步深化,这有利于扩展多巴胺的应用范围。
(2)多巴胺用于膜技术的表面功能改性,能改变膜的亲水性,提高抗油污能力,从而延长膜的使用寿命。然而在改性过程中其均一性和厚度很难把握,而这对于膜的水通量以及除污效果有很大影响。因此,寻找更方便可行的可大规模生产的均一、厚度可控的方法来对膜进行改性具有重要意义。
(3)目前,将多巴胺用于膜表面功能改性的研究不少,然而直接用于制备复合膜的研究相对来说还比较少,应加强此方面的研究,以利于开发新产品,控制生产 。
(4)对水污染中的3大类主要污染物:重金属离子、有机染料、微生物,前两者都已有多巴胺的应用研究,但对微生物方面的研究很少有涉及,而此类污染物对水体质量也有很大的影响力。可以运用多巴胺的特性进行该方面的研究,从而对污水中的微生物进行处理。
(5)研究具有效率高、易生化降解、原料来源丰富、制备成本低、广谱应用、易于循环利用、不造成二次污染等优点的用于吸附的多巴胺复合材料仍是研究者的一大挑战。
我国对多巴胺在水处理方面的研究和应用已取得了一定的进步,但对其产品的性能及应用的深入研究与国外相比还有一定的差距。因此,今后一方面,应加强对多巴胺作用机理以及实际应用性能的研究,稳定产品质量,促进产品的工业化;另一方面,应寻找改性产品的最佳适用条件并对其各种应用性能进行研究,从而使开发的新产品具有多种功能,设计更合理,应用面更广。














